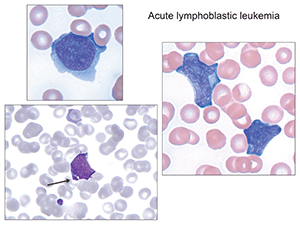
Fig.2. Arrowed image identifies azurophilic granules which can sometimes be seen, so-called granular acute lymphoblastic leukemia. (Images in Figs. 2–6 from Atlas of Peripheral Blood: The Primary Diagnostic Tool. Pereira I, George TI, Arber DA. Philadelphia: Wolters Kluwer/Lippincott Williams & Wilkins; 2012.)
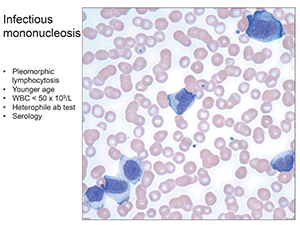
Fig.4. Infectious mononucleosis: Pleomorphic lymphocytosis, younger age, WBC < 50 x 109/L, heterophile ab test, serology.
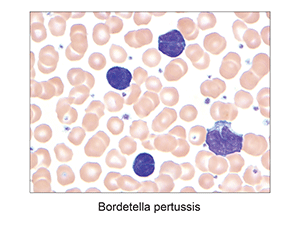
Fig.5. Bordetella pertussis

Karen Titus
February 2015—Like a modern-day Pericles, Tracy George, MD, had much to traverse in her overview of leukocytosis, thrombocytosis, and erythrocytosis during a course on diagnostic hematology at last year’s AACC meeting. Unlike Shakespeare’s Pericles, however, Dr. George navigated the many twists of her topic with the efficiency and near-encyclopedic knowledge of an experienced tour guide.
No magic here, in other words. Just the facts—but compelling ones.
Leukocytosis, the elevation of the white cell count for that patient’s age, by definition requires knowledge of the laboratory’s reference range. Producing a chart of her own lab’s ranges (Fig. 1), she noted that infants and children have reference ranges that are widely different from those of adults. But don’t take her word for it.
“You have to verify this in your own laboratory,” she said, noting that her own lab had recently done this after setting up a new hematology instrument. While validation is a relatively easy exercise for the adult population, “It’s much more challenging for the pediatric reference ranges.”

Most people use historical results from the literature. Hematology analyzers are, of course, designed to produce accurate, precise blood counts on normal specimens and to alert users to unusual characteristics that could lead to inaccurate measurements or require review of a blood smear. Typical flags, said Dr. George, include blasts, immature granulocytes, nucleated red blood cells, variant or atypical lymphocytes, platelet clumps, giant platelets, or problems with the red cell platelet overlap. Instruments also alert users to abnormalities likely to be associated with spurious results.
Put simply, “Flagged results require review,” said Dr. George, associate professor of pathology and chief of the hematopathology division, University of New Mexico and TriCore Reference Laboratories. “A slide review is appropriate in all patients with an unexplained leukocytosis.” This can be a so-called old-school approach, using a typical manual peripheral blood smear. Dr. George gave the example of a wedge-shaped smear, which, once stained, should be examined for a feathered edge. Laboratories can use newer automated image analysis systems—or even homegrown versions—as well.
Like a Stoic, Dr. George’s philosophy of leukocytosis rests comfortably in the practical. “This is how I think about leukocytosis: You have to confirm your CBC and differential first by examining your blood smear.” The next step in the diagnostic algorithm is to determine whether the case involves increased blasts; a myeloid leukocytosis, such as a granulocytosis or a monocytosis; or a lymphocytosis.
Offering several examples of acute lymphoblastic leukemia, Dr. George noted, in one slide, that at low power one can see an increased white cell count, with many smudge cells in the background. “Very fragile cells,” she said. On higher power, blasts become evident, with very high nuclear-to-cytoplasmic ratios, and with a very thin rim of cytoplasm. Blast size varies. In addition, she noted, anemia and thrombocytopenia accompany patients with acute leukemia, which also will be evident on the slide.
Dr. George would have happily concluded her remarks here, at the four-minute mark (and thus setting some sort of AACC presentation record). “If it was only that simple, right?” she joked, before offering additional examples of lymphoblastic leukemias.
In some cases, the cytoplasm is more abundant. Others, she laughed, “didn’t read the books” on what lymphoblastic leukemias should look like, and feature azurophilic granules. “We recently had a case at our institution [that] had so many granules that we even considered acute promyelocytic leukemia.” In still other cases, there will be L2-type lymphoblasts with abundant cytoplasm, which, in the example she presented, “dares to hug the red cell (Fig. 2). Those are the features we’re supposed to look at for reactive things,” she said, “and it’s mimicking it.”
In contrast, she also showed a case (Fig. 3) of hypogranular acute promyelocytic leukemia with “beautiful” folded nuclei. Those who look hard enough might also find the rare cell with multiple Auer rods to confirm the diagnosis. “Of course, it’s always important to distinguish acute promyelocytic leukemia from acute monocytic leukemia, which has more abundant cytoplasm,” with vacuoles and faint granules.
This was no off-the-cuff remark. “This truly is an emergency at every laboratory.” Such patients have a high risk for DIC and intracranial hemorrhage, so an immediate diagnosis is critical, either by FISH or PCR, looking for the fusion gene PML-retinoic acid receptor alpha, or PML-RARA. “In our own laboratory we start with a rapid cytochemical myeloperoxidase,” Dr. George said.
Labs typically will follow up with flow cytometry. “Most of these cases flow like myeloblasts and have loss or diminished expression of HLA-DR and, typically, CD34. But as we all know, that’s not pathognomonic. So you really have to do the FISH [or] PCR—whichever is faster in your laboratory.” These patients also require bone marrow examination as well as classical cytogenetic karyotyping.
“But you can also see blasts in other things like transient abnormal myelopoiesis associated with Down syndrome,” she continued. Thin, delicately tapered Auer rods are also characteristic in blasts from AML with t(8;21); AMLs can arise from myelodysplastic syndrome as well. These blasts are problematic, Dr. George cautioned, because they’re often smaller than normal myeloblasts. “They can look almost more like lymphocytes.”
If there are increased blasts, a bone marrow exam with flow cytometry, cytogenetics, and molecular genetics studies are in order. “This is just a general rule,” she explained, noting that in rare cases, pathologists are unable to obtain a bone marrow specimen. “We just had an eight-year-old [girl] who was extremely fragile, and we did all the studies on the peripheral blood.”
Lymphocytosis carries its own peculiarities. “If you’ve got a monomorphic lymphocytosis, suspect that you’re dealing with a neoplastic condition,” Dr. George said. On the other hand, in cases involving a pleomorphic lymphocytosis, where the lymphocytes vary in size and shape, “suspect that you’re dealing with a reactive lymphocytosis.”
The classic example of the latter is infectious mononucleosis (“the college student,” as Dr. George put it), with pleomorphic lymphocytosis, some with intensely basophilic cytoplasm. “You can even have more plasmacytic forms” (Fig. 4). It generally occurs at a younger age, with lower white counts— < 50 × 109/L. Good testing options include the Monospot test—the heterophile antibody—which can be done rapidly in most laboratories, or EBV serology. Young children will often be Monospot negative, she said, “so you’ll want to get serology.”

What causes reactive lymphocytosis? Among the culprits: viral and bacterial infections, toxoplasmosis, malaria, babesiosis, drug hypersensitivity, autoimmune disease, cytokines, vaccination, smoking, stress (such as trauma, cardiac events, even extreme exercise), endocrine disorders, and even secondary to malignancy.
There are exceptions to those “rules.” Dr. George offered the example of a case of lymphocytosis due to Bordetella pertussis (Fig. 5), the causative agent of “whooping cough,” marked by mature, deeply clefted lymphocytes. Given the patient’s young age, “A quick call to the clinician will confirm that you’re dealing with Bordetella.” It’s also possible to see similar lymphocytes in what’s known as polyclonal B-cell lymphocytosis, which tends to occur in young to middle-aged women who smoke.
In general, a monomorphic lymphocytosis offers a clue to a neoplastic process (Fig. 6). Among these is chronic lymphocytic leukemia, the cells of which have a particular look, to Dr. George’s eye: “I call them the little soccer balls. My colleague calls them snickerdoodles.” Another case, showing prolymphocytes with central nucleoli, was actually a prolymphocytoid transformation of CLL. A case of splenic marginal zone lymphoma showed “tufted” amounts of cytoplasm, what Dr. George called “a bipolar look.” Yet another case showed what looked like blasts. “We thought they were blasts,” she said. “This is why you do flow cytometry.” This case turned out to be a blastic mantle cell lymphoma, “the great mimicker.”
The morphology, in short, provides important clues about the case and how to approach it. “In general, with most of these, we recommend flow cytometry first, and then additional studies based on what we see by flow,” she said.
How often is there peripheral blood involvement in bone marrow lymphoma? Dr. George pointed to a study she and colleagues did (Arber DA, George TI. Am J Surg Pathol. 2005;29:1549–1557) involving nearly 200 samples. Almost 30 percent—57 samples—had involvement of the peripheral blood by morphology and flow cytometry. The study, which excluded CLL, showed a very high rate of involvement by marginal zone lymphoma (eight out of 10 samples, or 80 percent of cases with peripheral blood involvement); mantle cell lymphoma, 48 percent; Burkitt’s lymphoma, 40 percent; diffuse large B-cell lymphoma, 32 percent; and so on. “So it’s not uncommon to see,” she said.

Hematologists and family practitioners will often ask when flow cytometry should be performed on peripheral blood samples in adults. One study (Andrews JM, et al. Leuk Lymphoma. 2008;49:1731–1737) reviewed flow results of patients age 50 and older who had absolute lymphocytic counts ≥ 4 × 109/L. These cases—as so often happens—had already been called suspicious for a lymphoproliferative disorder after smear review by a pathologist. The researchers found that if the absolute lymphocytic count is > 6.7 × 109/L, or the patient’s age was 67 or older, “This had a sensitivity of 95 percent and a specificity of 76 percent in predicting an abnormal phenotype by flow cytometry.”
There’s nothing magical about the number 67, by the way. “It’s just fortuitous that the 67 appears in both,” said Dr. George. In general, older patients and higher lymphocyte counts are more likely to predict an abnormal flow phenotype.
Granulocytic (either neutrophilia, basophilia, or eosinophilia) and monocytic leukocytosis present challenges of their own. “Mostly what we’re seeing are reactive neutrophilias,” also known as neutrophilic leukemoid reactions. The problem, at its essence, is production of too many neutrophils. “You’re demarginating them,” said Dr. George. “Or you have decreased egress of neutrophils from the peripheral circulation to the tissues.” The overwhelming cause is infections, though it can also be seen with inflammation, drugs, malignancy, hemorrhage, smoking, or any strong stimulus to the bone marrow.
Common clues pointing to reactive neutrophilia is a lower white blood cell count (50 × 109/L), pronounced left shift, basophilia or eosinophilia, dacrocytes (i.e. teardrop-shaped RBCs), or dysplasia.
When it comes to monocytosis, most will be reactive, Dr. George said. Reactive monocytosis can be seen with malignancy, such as gastric carcinomas, multiple myelomas, and lymphomas; chronic infections; autoimmune disorders; after splenectomy; and especially in regenerating marrows after either chemotherapy or transplant. “Remember,” she told her AACC audience, “the monocytes come back first, before the granulocytes.”
It can be challenging to distinguish between a promonocyte and an abnormal mature monocyte. That’s when it’s important to bring up a differential diagnosis: acute myeloid leukemia (AML), chronic myelomonocytic leukemia, myelodysplastic syndrome/myeloproliferative neoplasm. All of these diagnoses require a bone marrow examination, said Dr. George—despite what she was once asked by an outside hematologist sending a case to her reference laboratory. “He said, ‘Can’t you tell by just flow?’ And I said, ‘We really can’t. I need to know what’s going on in the bone marrow to make sure that this is not acute leukemia in this patient.’”
Eosinophilia is defined as a prolonged eosinophil count: >1.5 × 109/L for at least six months. In the algorithm Dr. George presented, the first step is for clinicians to screen for the reactive causes of eosinophilia, a list that can go “on and on,” Dr. George said. Once those are screened out, clinicians need to examine the peripheral blood and bone marrow—at which point they’ll likely order flow cytometry and T-cell clonality studies to look for an abnormal T-cell clone that could be prompting eosinophilia, or for another malignancy, such as Hodgkin’s lymphoma, a T-cell lymphoma, certain types of acute lymphoblastic leukemia, or a clonal eosinophilia due to chronic myelogenous leukemia or certain types of AML. Once those have been excluded, it’s appropriate to assess for tyrosine kinase mutations. “We’re looking for myeloproliferative neoplasms with eosinophilia and either platelet-derived growth factor receptor alpha (PDGFRA), -beta (PDGFRB), or FGFR1.

With PDGFRB and FGFR1, said Dr. George, “You’ve got cytogenetic abnormalities that you’re going to see by classical karyotyping. So you’ve got to do the karyotyping.” But because PDGFRA is cytogenetically cryptic, FISH or PCR will need to be done to look for PDGFRA mutations or the so-called CHIC2 deletion. If those are negative, and if there’s clonality or more than one percent blasts in blood or more than five percent in bone marrow, “you can call it chronic eosinophilic leukemia.” Absent all these, then it’s a case of hypereosinophilic syndrome.
It’s important to identify PDGFRA, PDGFRB, or FGFR1 “because alpha and beta respond to very small doses of imatinib,” Dr. George explained. “Essentially, you can cure these patients.” And with FGFR1, researchers are looking at alternative small molecule inhibitors.
Basophilia is relatively straightforward. “Overwhelmingly, if you have a true basophilia on a peripheral blood smear, you’re dealing with something neoplastic,” usually chronic myelogenous leukemia or another myeloproliferative neoplasm. Automated hematology instruments aren’t good at identifying basophilia, Dr. George cautioned. “This is something where you really do have to scan the slide with some modality.” And in general, because there’s an overwhelming association of neoplasia with basophilia, bone marrows are a must.
Regarding thrombocytosis, Dr. George noted that acquired causes are much more common than congenital ones. The latter are usually due to gain of function mutations in thrombopoietin or in MPL (a thrombopoietin receptor). Acquired causes can be primary or secondary, with the latter much more common—reactive thrombocytosis represents 85 percent of cases. Platelet counts can reach >1 million/µL (normal platelet count is approximately 150,000 to 450,000/µL).
Reactive thrombocytosis can be transient or sustained. In the former, clues include acute blood loss, so-called rebound from thrombocytopenia, acute infection or inflammation, or response to exercise. Sustained reactive thrombocytopenia, on the other hand, can be seen in cases of iron deficiency, hemolytic anemia, and asplenia. It can occur—lasting up to several months—after splenectomy. It can also be seen in cancer, chronic inflammation or infectious diseases, and even in drug reactions.
An underlying systemic disease is much more common in reactive thrombocytosis, while ischemia, thrombosis, and bleeding complications are more characteristic of clonal thrombocytosis. “That’s why you have to identify these patients,” she said. Peripheral smears can be helpful—but only up to a point. “Generally, by the time you’re thinking about a clonal thrombocytosis you’re getting bone marrows.”
Dr. George ended her journey not at Mytilene, but by talking about erythrocytosis. Although it’s defined as a more than two standard deviation increase from age-, sex-, and race-adjusted norms in both the hematocrit and hemoglobin, “You know that hemoglobin and hematocrit are affected by plasma volume.” That means pathologists will, like many a Shakespeare character, need to distinguish between competing identities. Is it an apparent erythrocytosis or the true erythrocytosis? Apparent is due to a decrease in plasma volume, which gives the appearance of an increased RBC content. This occurs when a patient is dehydrated or when there’s a chronically contracted plasma volume—it’s not a true increase in RBC mass.
“The way we think about this now is clonal erythrocytosis versus nonclonal, where the clonal overwhelmingly have a JAK2, either V617F mutation or a JAK2 exon 12 mutation,” Dr. George said. “And nonclonals do not.”
Ideally, clinicians will know if they are dealing with apparent erythrocytosis, “so hopefully, you’re just dealing with the true erythrocytosis.” It’s typical to start with JAK2 testing, reflexing to JAK2 exon 12 mutation testing if the JAK2 V617F is negative. In more than 95 percent of cases of polycythemia vera, JAK2 test results will be positive. In the remaining cases, erythropoietin testing should be done. “If it’s normal or increased EPO, then you’re dealing with an acquired erythrocytosis.”
Primary erythrocytosis is, typically, polycythemia vera. On a practical level—WHO classification be damned—clinicians look for an elevated hemoglobin, Dr. George said. If it’s normal, but they still suspect polycythemia vera, then they look for causes of a masked erythrocytosis, such as a concurrent iron deficiency anemia. They’ll look for one of the JAK2 mutations. “And they’ll look for a low or sometimes a normal EPO level.”
Bone marrow testing, in these cases, is conspicuous by its absence, Dr. George said. “I think we all are seeing this—for patients with suspected polycythemia vera, a bone marrow is generally not being performed until very late in the stage, where the patient then progresses to cytopenias and is developing post-polycythemic myelofibrosis.”
[hr]
A few nuggets of advice
Dr. George offered these additional tips as part of her AACC presentation:
- “It’s key that you have a properly prepared blood smear to determine the etiology of anemia, cytopenias, and leukocytosis, whether you’re looking at it manually or with one of these image analysis systems. For isolated anemias, CBC parameters and reticulocyte count can help you determine a differential diagnosis. And you can use the peripheral blood smear and red cell morphology abnormalities to refine your differential diagnosis and determine what follow-up testing you’ll do.”
- “It’s important to exclude pseudothrombocytopenia and pseudoneutropenia before you undertake additional workups. And a peripheral blood smear review for cytopenias is often useful to detect clinically significant disorders, narrow diagnostic considerations, and focus your additional workup.”
- “Infections can result in cytopenias. And some organisms can be identified on the peripheral smear review.”
- “In patients with cytopenias, abnormal cells may be infrequent, but they can have significant impact on diagnosis and further workup. It’s important to rule out reactive causes first before jumping to the diagnosis of a malignant neoplasm. And it still remains true: a pleomorphic lymphocytosis favors a reactive lymphocytosis. But a monomorphic lymphocytosis should trigger additional ancillary studies in the correct setting.”
- “Neutrophilic leukemoid reactions are much more common than myeloid malignancies. Clues that you’re dealing with one of these leukemoid reactions include activated neutrophils and lower white cell counts. But if you are suspicious for a myeloid malignancy, then you need to perform a bone marrow examination as well as additional ancillary testing, which can include flow if blasts are elevated.”
[hr]
Karen Titus is CAP TODAY contributing editor and co-managing editor.

